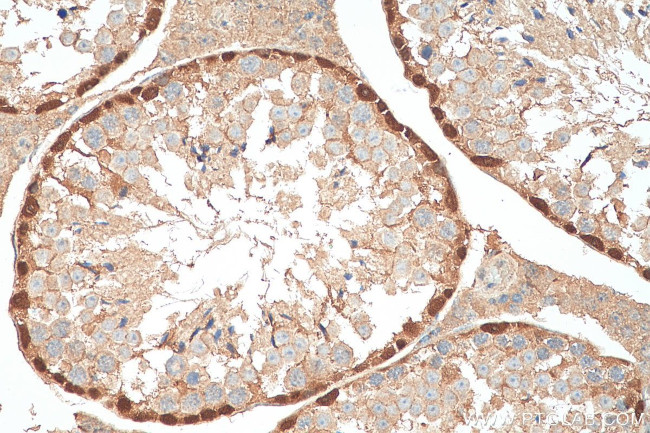
DMRT1 Antibody in Immunohistochemistry (Paraffin) (IHC (P))

Search
Proteintech
DMRT1 Polyclonal Antibody
{{$productOrderCtrl.translations['antibody.pdp.commerceCard.promotion.promotions']}}
{{$productOrderCtrl.translations['antibody.pdp.commerceCard.promotion.viewpromo']}}
{{$productOrderCtrl.translations['antibody.pdp.commerceCard.promotion.promocode']}}: {{promo.promoCode}} {{promo.promoTitle}} {{promo.promoDescription}}. {{$productOrderCtrl.translations['antibody.pdp.commerceCard.promotion.learnmore']}}
产品信息
14313-1-AP150UL
种属反应
宿主/亚型
分类
类型
偶联物
形式
浓度
规格
纯化类型
保存液
内含物
保存条件
运输条件
靶标信息
This gene is found in a cluster with two other members of the gene family, having in common a zinc finger-like DNA-binding motif (DM domain). The DM domain is an ancient, conserved component of the vertebrate sex-determining pathway that is also a key regulator of male development in flies and nematodes. This gene exhibits a gonad-specific and sexually dimorphic expression pattern. Defective testicular development and XY feminization occur when this gene is hemizygous.
仅用于科研。不用于诊断过程。未经明确授权不得转售。
篇参考文献 (0)
生物信息学
蛋白别名: DM domain expressed in testis 1; DM domain expressed in testis protein 1; DMRT1; Doublesex- and mab-3-related transcription factor 1; unnamed protein product
基因别名: CT154; DMRT1; DMT1
UniProt ID: (Human) Q9Y5R6, (Mouse) Q9QZ59
Entrez Gene ID: (Human) 1761, (Mouse) 50796, (Rat) 114498